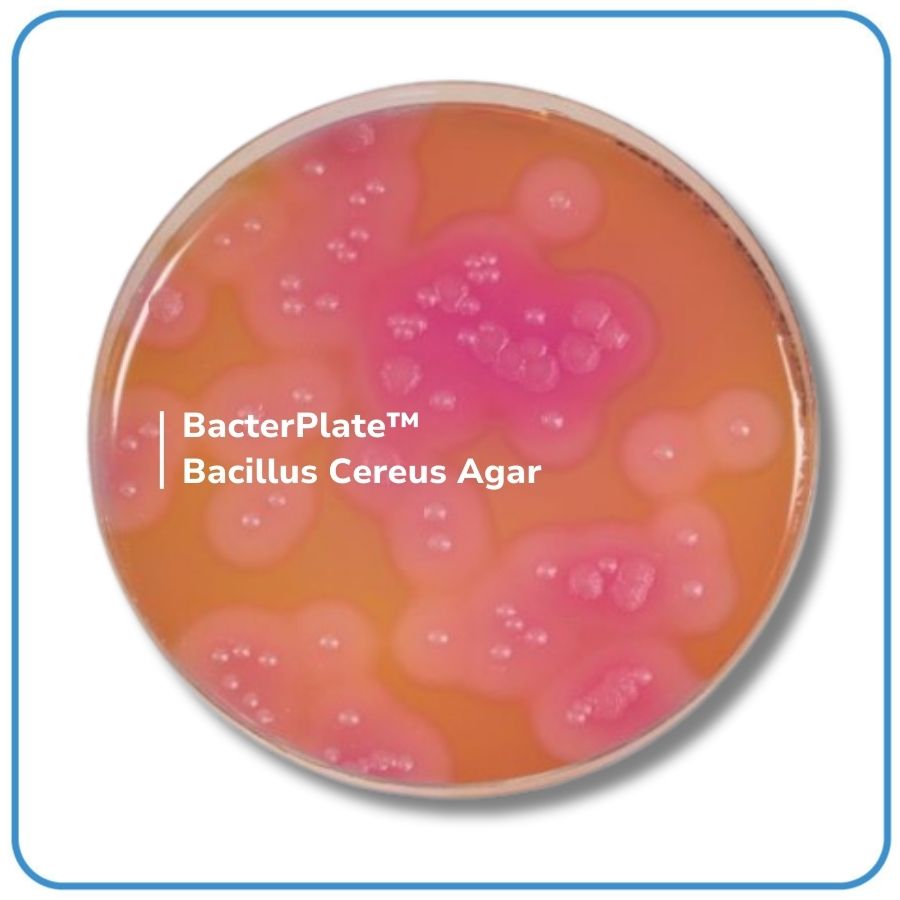

BacterPlate™ Bacillus cereus Agar
Mã: 05036
Mã đặt hàng/sản phẩm: 4102032
Số lượng tối thiểu: 1
Qui cách đóng gói:
10 đĩa/hộp
BacterPlate™ Bacillus cereus Agar được sử dụng để phát hiện và định lượng bào tử cũng như tế bào sinh dưỡng của Bacillus cereus trong các sản phẩm thực phẩm. Môi trường này được dùng để định lượng Bacillus cereus từ mẫu nghi ngờ ở 30°C theo tiêu chuẩn (NF EN ISO 7932). Nó cũng được khuyến nghị trong phương pháp phát hiện hoặc phương pháp định lượng với số lượng nhỏ theo tiêu chuẩn NF EN ISO 21871.
- Thành phần: Nutrient system; Sodium chloride; Selective system; Chromogenic substrate; Agar.
- pH của môi trường hoàn chỉnh ở 25°C: 7,0 ± 0,2.
- Quy cách: 10 đĩa/ hộp hoặc theo yêu cầu của khách hàng.
- Bảo quản lưu trữ: 2 - 8°C.
- Vận chuyển: Nhiệt độ môi trường.
- Hạn sử dụng: 04 tháng kể từ ngày sản xuất.
Danh sách đặt hàng
BacterPlate™ Bacillus cereus Agar
Mã: 4102032
Đơn vị: Đĩa
| Tên sản phẩm | Hình ảnh | Mã đặt hàng/sản phẩm | Đơn vị tính | Số lượng | Chọn vào giỏ hàng |
|---|---|---|---|---|---|
| BacterPlate™ Bacillus cereus Agar | ![]() | 4102032 | Đĩa |
